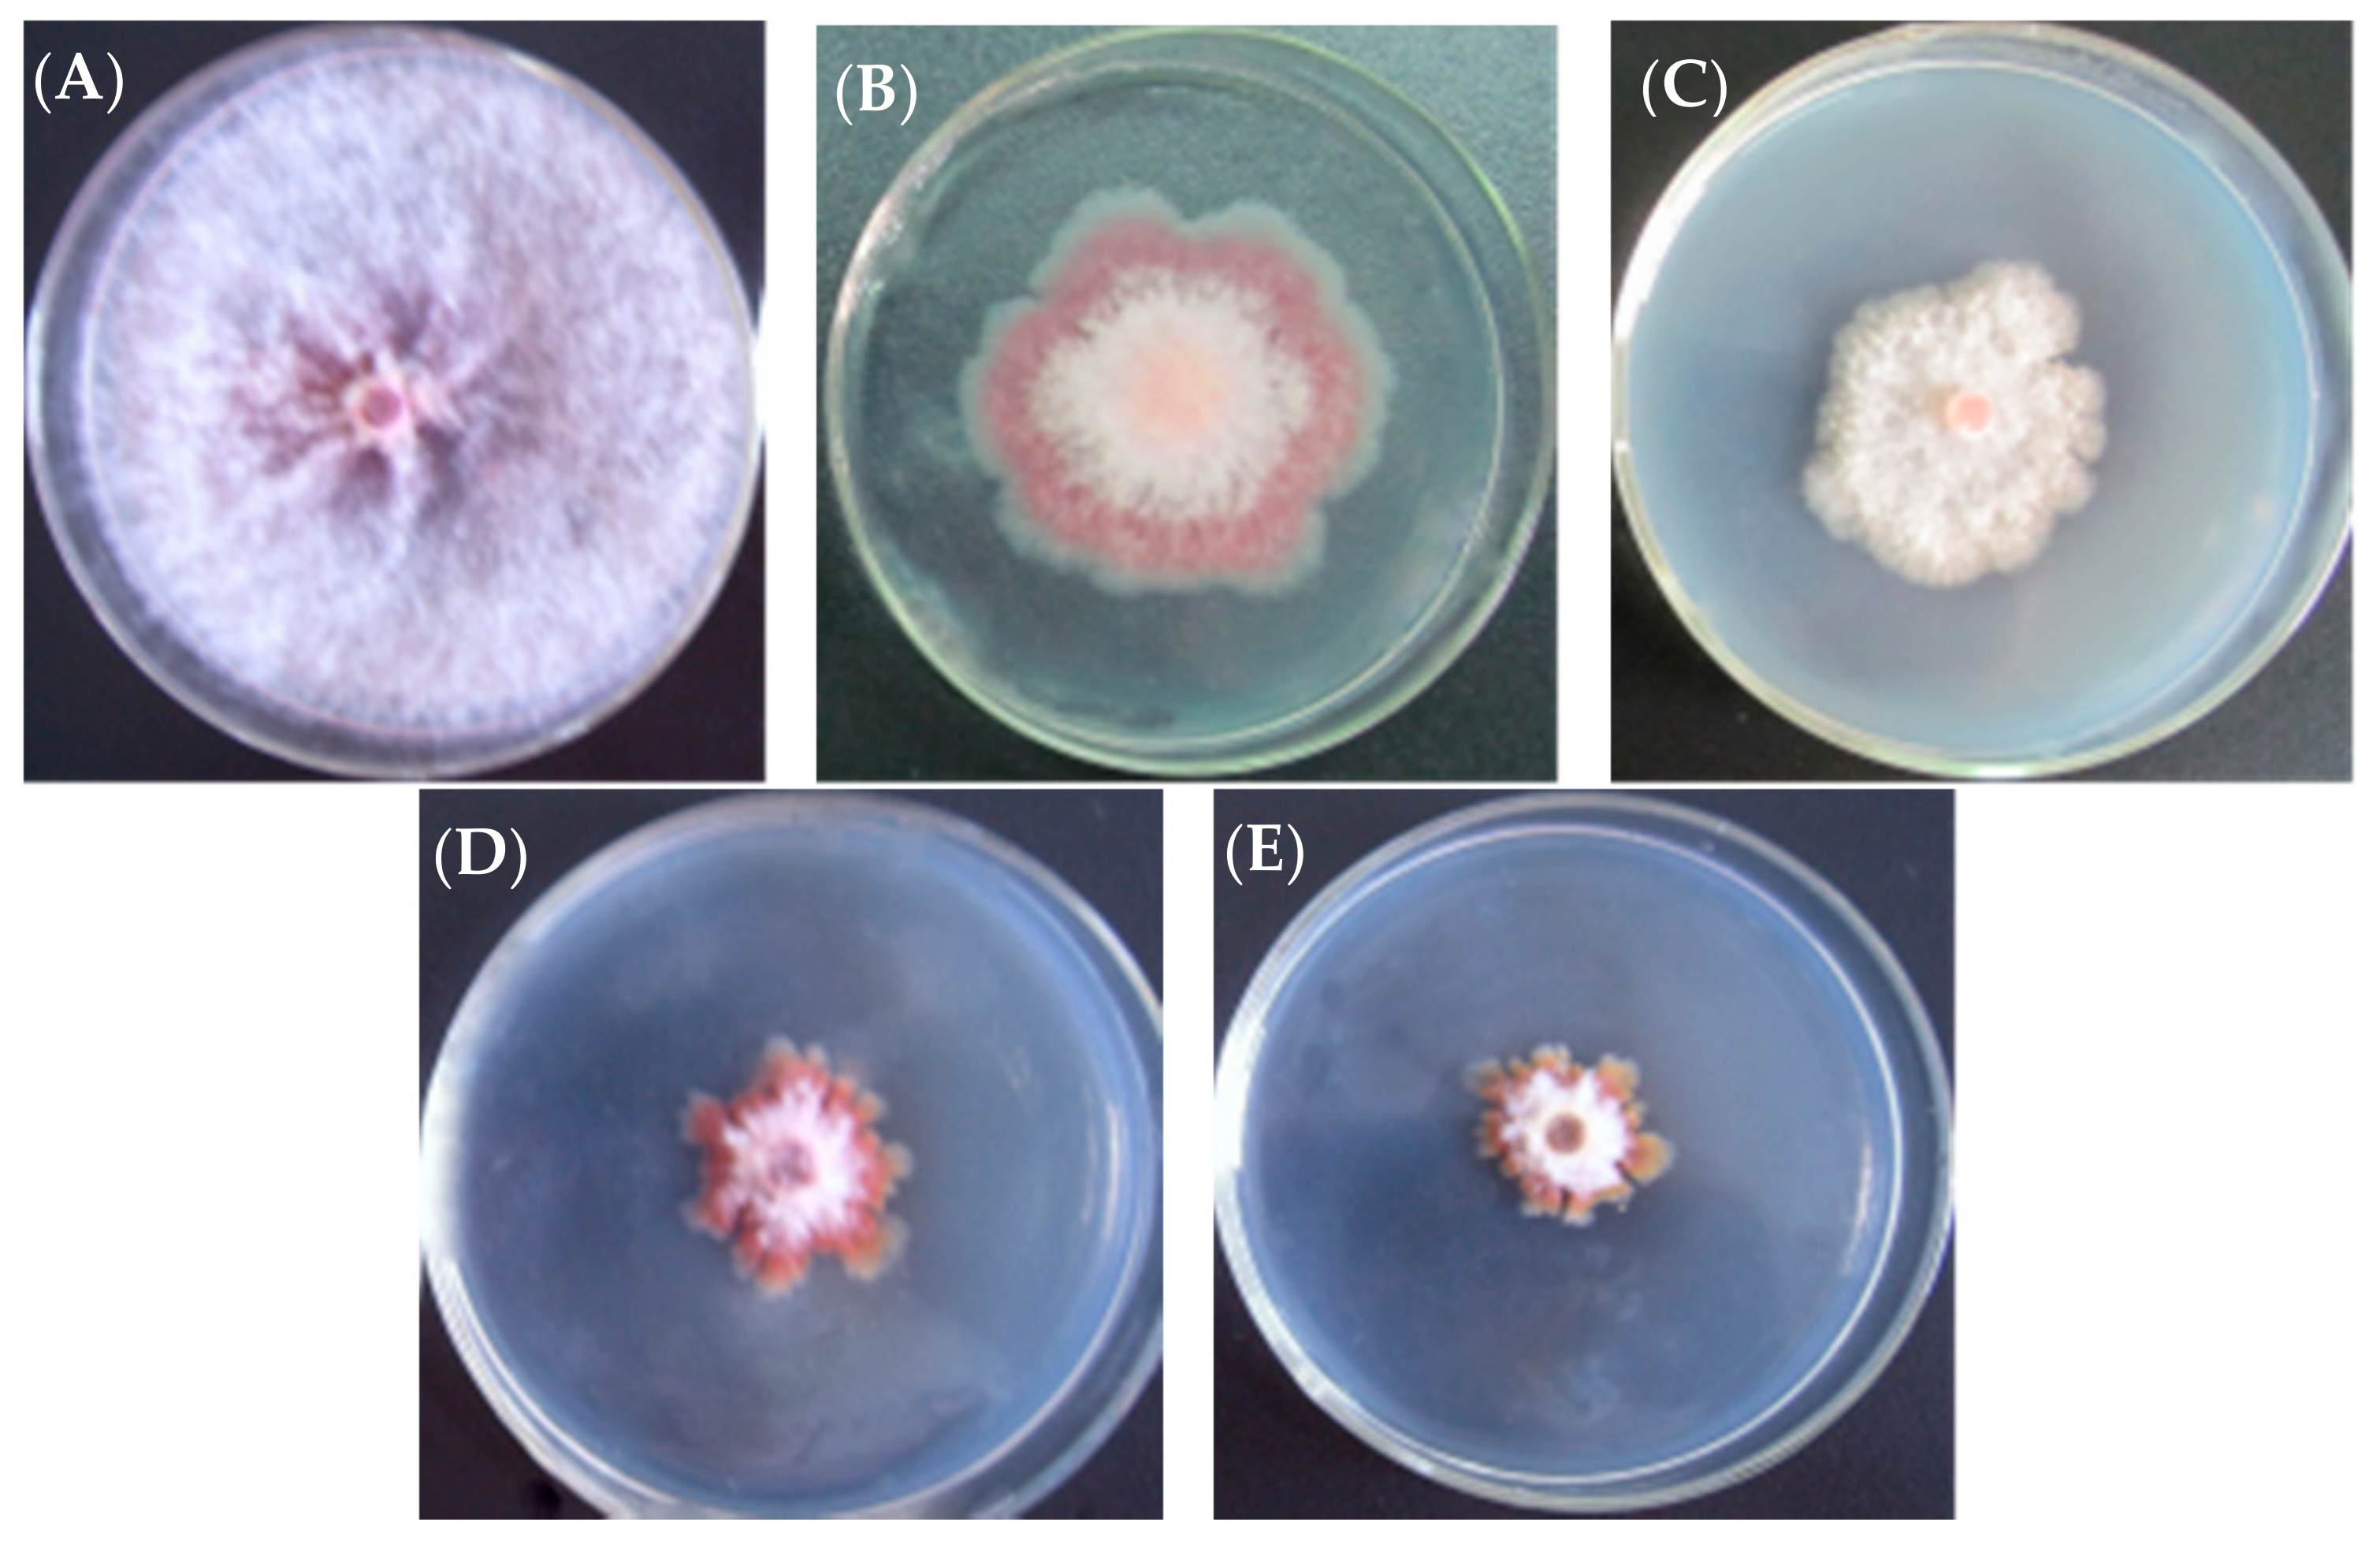
Molecules 22 02224 g003

A Novel Antibiotic Mechanism of l-Cyclopropylalanine Blocking the Biosynthetic Pathway of Essential Amino Acid l-Leucine
Abstract
:1. Introduction
2. Results and Discussion
2.1. Anti-Fungal Activity of l-Cyclopropylalanine and Its Derivatives
2.2. Anti-Fungal Effect of l-Cyclopropylalanine Reversed by l-Leucine
2.3. Inhibition of α-IPMS by l-Leucine and l-Cyclopropylalanine
2.4. Inhibitory Effect of l-Cyclopropylalanine against S. cererisiae, C. albicans and E. coli
2.5. Discussion
3. Materials and Methods
3.1. Chemicals and Materials
3.2. Anti-Fungal Test In Vitro and Isolation of the l-Cyclopropylalanine
3.3. Animals
3.4. Cloning of the leuA Gene by PCR Amplification
3.5. Protein Expression and Purification
3.6. Enzyme Assay
4. Conclusions
Supplementary Materials
Acknowledgments
Author Contributions
Conflicts of Interest
References
- János, B. Thoughts and facts about antibiotics: Where we are now and where we are heading. J. Antibiot. 2012, 65, 385–395. [Google Scholar]
- Newman, D.J.; Cragg, G.M.; Snader, K.M. The influence of natural products upon drug discovery. Nat. Prod. Rep. 2000, 17, 215–234. [Google Scholar] [CrossRef] [PubMed]
- Newman, D.J.; Cragg, G.M. Natural products as sources of new drugs over the last 25 years. J. Nat. Prod. 2007, 70, 981–990. [Google Scholar] [CrossRef] [PubMed]
- Tomihisa, O.; Shigeru, N.; Zenji, S.; Toshio, A.; Shi-ichi, H.; Shigo, N. Cyclopropylalanine, an antifungal amino acid of the mushroom Amanita virgneoides BAS. Chem. Lett. 1986, 15, 511–512. [Google Scholar]
- Gunter, B.K. Leucine biosynthesis in fungi: Entering metabolism through the back door. Microbiol. Mol. Biol. Rev. 2003, 67, 1–15. [Google Scholar]
- Beltzer, J.P.; Chang, L.; Hikkaneen, A.E.; Kohlhaw, G.B. Structure of yeast Leu4. J. Biol. Chem. 1986, 261, 5160–5167. [Google Scholar] [PubMed]
- Chanchaem, W.; Palittapongranpim, P. A variable number of tandem repeats result in polymorphic α-isopropylmalate synthase in Mycobacterium tuberculosis. Tuberculosis 2002, 81, 1–6. [Google Scholar] [CrossRef] [PubMed]
- Kraker, J.W.; Luck, K.; Textor, S. Two Arabidopsis genes (IPMS1 and IPMS2) encode is α-isopropylmalate synthase, the branchpoint step in the biosynthesis of leucine. Plant Physiol. 2007, 143, 970–986. [Google Scholar] [CrossRef] [PubMed]
- Yindeeyoungyron, W.; Supaporn, L.S.; Prasit, P.P. Characterization of α-isopropylmalate synthase containing different copy numbers of tandem repeats in Mycobacterium tuberculosis. BMC Microbiol. 2009, 9, 122–131. [Google Scholar] [CrossRef] [PubMed]
- Konn, N.; Squire, C.J.; Baker, E.N. Crystal structure of LeuA from Mycobacterium tuberculosis, a key enzyme in leucine biosynthesis. Proc. Natl. Acad. Sci. USA 2004, 101, 8295–8300. [Google Scholar] [CrossRef] [PubMed]
- Der Carvalho, L.P.S.; Argyrou, A.; Blanchard, J.S. Slow-onset feedback inhibition: Inhibition of Mycobacterium tuberculosis α-isopropylmalate synthase by leucine. J. Am. Chem. Soc. 2005, 127, 10004–10005. [Google Scholar] [CrossRef] [PubMed]
- Martinez, J.P.; Sasse, F.; Brönstrup, M.; Diez, J.; Meyerhans, A. Antiviral drug discovery: Broad-spectrum drugs from nature. Nat. Prod. Rep. 2015, 32, 29–48. [Google Scholar] [CrossRef] [PubMed]
- Mark, S.B.; Antony, D.B. Natural products-The future scaffolds for novel antibiotics? Biochem. Pharmacol. 2006, 71, 919–929. [Google Scholar]
- Dennis, C.D.; William, S.C. Characterization and toxicity of Amanita cokeri extract. J. Chem. Ecol. 2002, 28, 333–341. [Google Scholar]
- Mohana, D.C.; Raveesha, K.A. Anti-fungal evaluation of some plant extracts against some plant pathogenic field and storage fungi. J. Agric. Technol. 2007, 4, 119–137. [Google Scholar]
Sample Availability: Samples of the compounds are not available from the authors. |

| Pathogen Fungi | l-Cyclopropylalanine | Carbendazim ** | ||
|---|---|---|---|---|
| IR * at 50 μg/mL | IR at 5 μg/mL | IR at 50 μg/mL | IR at 5 μg/mL | |
| Fusarium graminearum Schw | 77.2 | 65.5 | 22.7 | 8.6 |
| Fusarium moniliforme | 74.1 | 22.6 | 3.8 | 2.5 |
| Colletotrichum gloeosporioides Penz | 74.9 | 29.6 | 72.2 | 21.8 |
| Sclerotinia sclerotiorum (Lib.) de Bary | 100 | 20.8 | 100 | 8.0 |
| Ascochyta gossypii Syd. | 86.2 | 44.9 | 0 | 0 |
| Alternaria solani | 69.8 | 10.6 | 0 | 0 |
| Corynespora cassiicola | 69.0 | 42.0 | 0 | 0 |
| Colletotrichum capsici | 62.1 | 24.4 | 0 | 0 |
| Alternaria alternaria f. sp. mali | 58.1 | 30.2 | 0 | 0 |
| Alternaria brassicae (Berk.) Sacc. | 57.4 | 29.8 | 2.8 | 0 |
| Cercospora arachidicola Hori | 56.8 | 28.1 | 2.5 | 0 |
| Cladosporium ladosporium | 53.4 | 26.6 | 0 | 0 |
© 2017 by the authors. Licensee MDPI, Basel, Switzerland. This article is an open access article distributed under the terms and conditions of the Creative Commons Attribution (CC BY) license (http://creativecommons.org/licenses/by/4.0/).
Share and Cite
Ma, B.; Shen, J.; Yindeeyoungyeon, W.; Ruan, Y. A Novel Antibiotic Mechanism of l-Cyclopropylalanine Blocking the Biosynthetic Pathway of Essential Amino Acid l-Leucine. Molecules 2017, 22, 2224. https://doi.org/10.3390/molecules22122224
Ma B, Shen J, Yindeeyoungyeon W, Ruan Y. A Novel Antibiotic Mechanism of l-Cyclopropylalanine Blocking the Biosynthetic Pathway of Essential Amino Acid l-Leucine. Molecules. 2017; 22(12):2224. https://doi.org/10.3390/molecules22122224
Chicago/Turabian StyleMa, Bingji, Jinwen Shen, Wandee Yindeeyoungyeon, and Yuan Ruan. 2017. "A Novel Antibiotic Mechanism of l-Cyclopropylalanine Blocking the Biosynthetic Pathway of Essential Amino Acid l-Leucine" Molecules 22, no. 12: 2224. https://doi.org/10.3390/molecules22122224
APA StyleMa, B., Shen, J., Yindeeyoungyeon, W., & Ruan, Y. (2017). A Novel Antibiotic Mechanism of l-Cyclopropylalanine Blocking the Biosynthetic Pathway of Essential Amino Acid l-Leucine. Molecules, 22(12), 2224. https://doi.org/10.3390/molecules22122224
